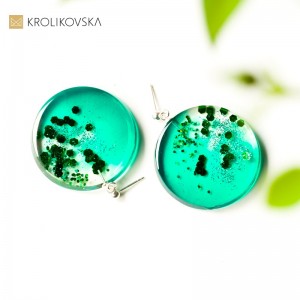
Kolczyki zielone, duże koła na wkrętkach.

Artystyczne Naszyjniki: Ręcznie Malowana Biżuteria jako Idealny Prezent.
Artystyczne Naszyjniki: Ręcznie Malowana Biżuteria jako Idealny Prezent. Prezent sztuka w naszyjniku. Grafikę, którą oglądasz namalowałam tuszami....
Bransoletki dla mamy-biały jadeit malowany ręcznie i srebro
Bransoletki dla mamy-biały jadeit malowany ręcznie i srebro. Bransoletki dla mamy-biały jadeit malowany ręcznie i srebro 925 - kamień ten był...
Naszyjniki Artystyczne na Zamówienie: Twój Unikalny Styl.
Naszyjniki Artystyczne na Zamówienie: Twój Unikalny Styl. Awangarda nowoczesna biżuteria. Naszyjnik damski w prezencie to bardzo klasyczny pomysł....
Biżuteria artystyczna czarno złota.
Biżuteria artystyczna czarno złota. Zaprojektowana i wykonana przez artystkę-jubilerkę Marzenę Królikowską-Kukułę, kolekcja powstała z myślą o...
Naszyjnik autorski, kwiaty zatopione w żywicy.
Naszyjnik autorski, kwiaty zatopione w żywicy. Zaprojektowana i wykonana przez artystkę-jubilerkę Marzenę Królikowską-Kukułę, kolekcja powstała z...
Ekskluzywny Naszyjnik z Malowaną Zawieszką – Unikatowy Prezent.
Prezent sztuka w naszyjniku. Ekskluzywny Naszyjnik z Malowaną Zawieszką – Unikatowy Prezent. Grafikę, którą oglądasz namalowałam tuszami. Jest to...
Prezent artystyczny z kwiatami dla szwagierki.
Prezent artystyczny z kwiatami dla szwagierki. Awangarda nowoczesna biżuteria. Naszyjnik damski w prezencie to bardzo klasyczny pomysł. Chcemy...
Kreacja Artystyczna - Pierścionek Wyjątkowej Jakości Stworzony z Miłością.
Kreacja Artystyczna - Pierścionek Wyjątkowej Jakości Stworzony z Miłością. Pierścionek z kwiatami. Malarski pierścionek z zatopiony kwiatami w...
Biżuteria z żywicy handmade – unikalny dodatek grafiką.
Elegancki naszyjnik.Biżuteria z żywicy handmade – unikalny dodatek grafiką.Naszyjnik damski w prezencie to bardzo klasyczny pomysł.Chcemy obdarować...